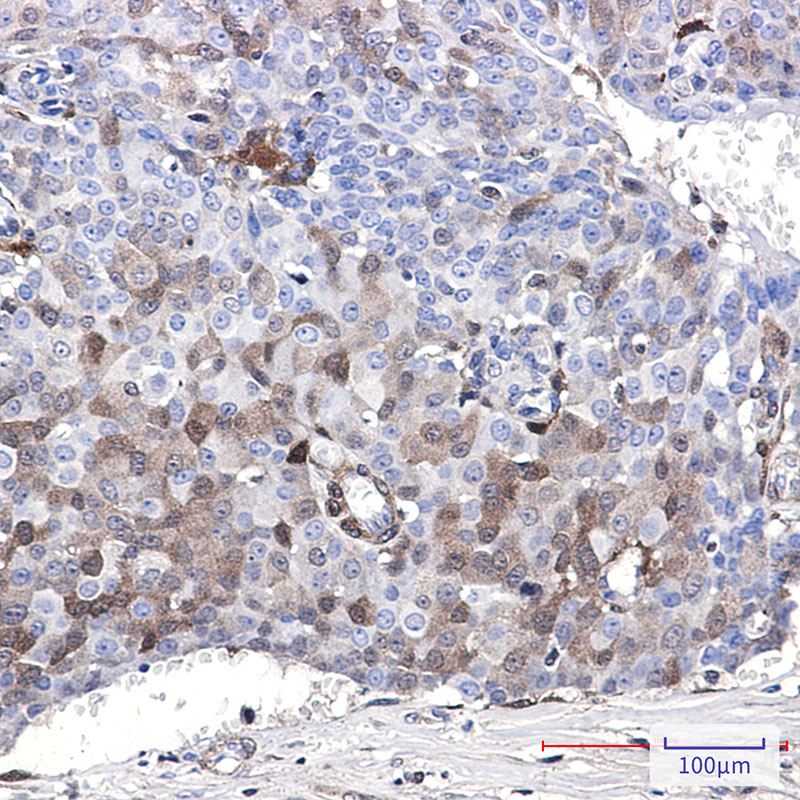

-
分类: 科研抗体货号: P21789别名: CDKN1A; CAP20; CDKN1; CIP1; MDA6; PIC1; SDI1; WAF1; Cyclin-dependent kinase inhibitor 1; CDK-interacting protein 1; Melanoma differentiation-associated protein 6; MDA-6; p21应用: WB反应种属: Human,Mouse
-
分类: 科研抗体货号: P21788别名: CDKN2C; CDKN6; Cyclin-dependent kinase 4 inhibitor C; Cyclin-dependent kinase 6 inhibitor; p18-INK4c; p18-INK6应用: WB,IP,IHC反应种属: Human,Mouse,Rat
-
分类: 科研抗体货号: P21807别名: CDHP; CDHE; HJMD; PCAD; CDHN; P-cadherin; E-cadherin; N-cadherin; Cadherin-1; Cadherin-2; Cadherin-3应用: WB,IP,IHC,IF反应种属: Human,Mouse,Rat,Hamster
-
分类: 科研抗体货号: P21787别名: CHAF1A; CAF; CAF1P150; Chromatin assembly factor 1 subunit A; CAF-1 subunit A; Chromatin assembly factor I p150 subunit; CAF-I 150 kDa subunit; CAF-I p150; hp150应用: WB,IP,IHC,IF反应种属: Human
-
分类: 科研抗体货号: P21806别名: PAK2; Serine/threonine-protein kinase PAK 2; Gamma-PAK; PAK65; S6/H4 kinase; p21-activated kinase 2; PAK-2; p58应用: WB,IHC反应种属: Human,Mouse,Rat
-
分类: 科研抗体货号: P21786别名: p-pg; ABCB1; MDR1; PGY1; Multidrug resistance protein 1; ATP-binding cassette sub-family B member 1; P-glycoprotein 1; CD antigen CD243应用: WB反应种属: Human
-
分类: 科研抗体货号: P21804别名: poly(A) binding protein interacting protein 1应用: WB,IP,IHC,IF反应种属: Human,Mouse,Rat
-
分类: 科研抗体货号: P21785别名: OTUB1; OTB1; OTU1; HSPC263; Ubiquitin thioesterase OTUB1; Deubiquitinating enzyme OTUB1; OTU domain-containing ubiquitin aldehyde-binding protein 1; Otubain-1; hOTU1; Ubiquitin-specific-processing protease OTUB1应用: WB,IP反应种属: Human,Mouse,Rat
-
分类: 科研抗体货号: P21803别名: SERPINE1; PAI1; PLANH1; Plasminogen activator inhibitor 1; PAI; PAI-1; Endothelial plasminogen activator inhibitor; Serpin E1应用: WB,IP,IF反应种属: Human,Mouse,Rat
-
分类: 科研抗体货号: P21784别名: Grp170; HSP12A; Hyou1; Orp150应用: WB,IP,IHC,IF反应种属: Human

鄂公网安备42018502007531号
鄂公网安备42018502007531号

